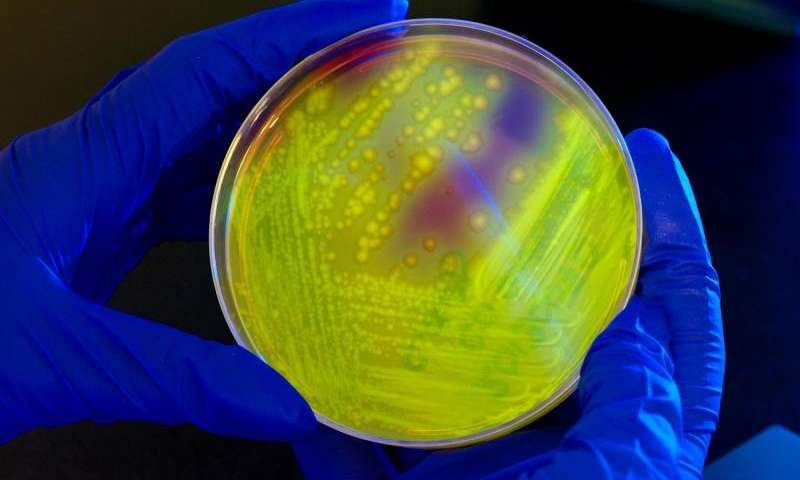

http://www.healthcaredive.com/news/an-aca-primer-much-more-than-insurance/429497/

Remember the Affordable Care Act? Enacted in 2010, it expanded healthcare insurance to millions of uninsured Americans and increased access to care. But the ACA is much more than expanded coverage; it set in motion a variety of reforms in the healthcare delivery systems aimed at lowering costs and improving quality of care.
That fact was lost on presidential candidate Donald Trump, who told Fox News recently, “I don’t use much Obamacare, I must be honest with you, because it is so bad for the people and they can’t afford it.” Trump’s comments imply Obamacare is an insurance plan people can buy, which is not the case. As we wrap up year six since the ACA was enacted, here‘s what the law is really about and how it impacts providers.